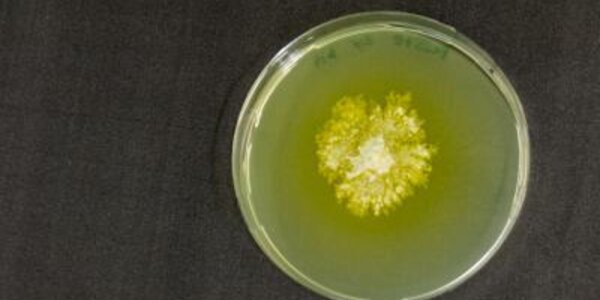
Article teaser image

Microfluidic Electrolyzer: Testing Artificial Photosynthesis
With nuclear power trapped in committee meetings and biofuels exposed as a bad idea, the search for another carbon-neutral alternative is ongoing.
While the sun gives us enough energy in an hour to…